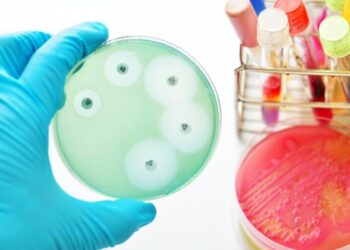
Бактериальный эпсилон токсин, обнаруженный у пациентов с РС, вызывает признаки заболевания РС у грызунов

Разгадка тайн РС
Разгадана тайна рассеянного склероза
Нейровоспаление как топливо для регенерации аксонов в центральной нервной системе
Повреждение центральной нервной системы (ЦНС) является одной из основных причин заболеваемости и смертности у пожилых людей, поскольку восстановление после повреждений...
ЧИТАТЬ ВСЕИнфекционная этиология Рассеянного склероза
Вирусные инфекции вызывают различные демиелинизирующие заболевания у животных и людей. Возможные механизмы вирусной демиелинизации Вирусная инфекция олигодендроцитов или шванновских клеток,...
ЧИТАТЬ ВСЕБактериальный эпсилон токсин, обнаруженный у пациентов с РС, вызывает признаки заболевания РС у грызунов
Согласно данным, представленным на 4- м ежегодном форуме Американского комитета по лечению и исследованиям рассеянного склероза (ACTRIMS), уровни эпсилон-токсина повышены у пациентов с рассеянным склерозом (РС), а его...
ЧИТАТЬ ВСЕДоказательства наличия эпсилон-токсина Clostridium perfringens, связанного с рассеянным склерозом
Предпосылки: недавно сообщалось, что с помощью вестерн-блоттинга у некоторых пациентов с рассеянным склерозом (РС) в Соединенных Штатах были антитела против эпсилон-токсина...
ЧИТАТЬ ВСЕРассеянный склероз может быть вызван токсином
Исследователи из Медицинского колледжа Вейл Корнелл добавили к растущему числу доказательств того, что рассеянный склероз может быть вызван токсином, вырабатываемым...
ЧИТАТЬ ВСЕ